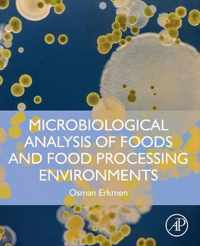
Microbiological Analysis of Foods and Food Processing Environments

principles of microbiological troubleshooting in the industrial food processing environment online kopen
Ben je op zoek naar principles of microbiological troubleshooting in the industrial food processing environment? Bekijk onze boeken selectie en zie direct bij welke webshop je principles of microbiological troubleshooting in the industrial food processing environment online kan kopen. Ga je voor een ebook of paperback van principles of microbiological troubleshooting in the industrial food processing environment. Zoek ook naar accesoires voor principles of microbiological troubleshooting in the industrial food processing environment. Zo ben je er helemaal klaar voor. Ontdek ook andere producten en koop vandaag nog je principles of microbiological troubleshooting in the industrial food processing environment met korting of in de aanbieding. Alles voor veel leesplezier!
Principles of Microbiological Troubleshooting in the Industrial Food Processing Environment
Principles of Microbiological Troubleshooting in the Industrial Food Processing Environment provides proven approaches and suggestions for;
Vergelijkbare producten zoals Principles of Microbiological Troubleshooting in the Industrial Food Processing Environment
Microorganisms in Foods 8
appropriate testing of food processing environments, processing lines, and finished product to enhance the safety and microbiological quality of the;
Vergelijkbare producten zoals Microorganisms in Foods 8
Microbiological Risk Assessment in Food Processing
Microbiological risk assessment (MRA) is one of the most important recent developments in food safety management. Adopted by Codex;
Vergelijkbare producten zoals Microbiological Risk Assessment in Food Processing
Hygiene In Food Processing 2nd
chapter on microbiological sampling explains how to calculate the risk of contamination depending on the product's environment. This;
Vergelijkbare producten zoals Hygiene In Food Processing 2nd
Microorganisms in Foods 7: Microbiological Testing in Food Safety Management
The second edition of Microorganisms in Foods 7: Microbiological Testing in Food Safety Management updates and expands on information on;
Vergelijkbare producten zoals Microorganisms in Foods 7: Microbiological Testing in Food Safety Management
Microbiology of Food Quality
With consumer awareness increasing, the importance of the environmental impact of everyday products such as food becomes a major factor for;
Vergelijkbare producten zoals Microbiology of Food Quality
Microorganisms in Foods 7
The second edition of Microorganisms in Foods 7: Microbiological Testing in Food Safety Management updates and expands on information on;
Vergelijkbare producten zoals Microorganisms in Foods 7
High Pressure Processing of Food
High pressure processing technology has been adopted worldwide at the industrial level to preserve a wide variety of food products without;
Vergelijkbare producten zoals High Pressure Processing of Food
Microorganisms in Foods 5
in foods and the food processing environment. Detailed information about each of the main organisms responsible for causing microbial food;
Vergelijkbare producten zoals Microorganisms in Foods 5
Food Processing Waste Management
contents have been divided into 14 s namely; Food Processing Industrial Wastesu Present Scenario, Impact of Food Industrial Waste on Environment;
Vergelijkbare producten zoals Food Processing Waste Management
Microbiological Analysis of Foods and Food Processing Environments
Microbiological Analysis of Foods and Food Processing Environments is a well-rounded text that focuses on food microbiology laboratory;
Vergelijkbare producten zoals Microbiological Analysis of Foods and Food Processing Environments
Food Processing Handbook
technology involved, this handbook describes the principles and the equipment used as well as the changes - physical, chemical, microbiological and;
Vergelijkbare producten zoals Food Processing Handbook
An Evaluation of the Role of Microbiological Criteria for Foods and Food Ingredients
Appendixes A Summary Responses to Specific Contract Items B General Principles for the Establishment and Application of Microbiological Criteria;
Vergelijkbare producten zoals An Evaluation of the Role of Microbiological Criteria for Foods and Food Ingredients
Food Processing
Food Processing: Principles and Applications is a comprehensive resource that explores the basic and applied aspects of food processing. It;
Vergelijkbare producten zoals Food Processing
Microbial Control and Food Preservation
This edited volume provides up-to-date information on recent advancements in efforts to enhance microbiological safety and quality in the;
Vergelijkbare producten zoals Microbial Control and Food Preservation
Microbial Control and Food Preservation
This edited volume provides up-to-date information on recent advancements in efforts to enhance microbiological safety and quality in the;
Vergelijkbare producten zoals Microbial Control and Food Preservation
Radio-Frequency Heating in Food Processing
overview of the fundamental science and engineering principles governing RF applications, as well as a solid understanding of industrial RF unit;
Vergelijkbare producten zoals Radio-Frequency Heating in Food Processing
Applications of Membrane Technology for Food Processing Industries
professors, scientist, research scholars, students and industrial personnel, will come to know about the current trends in use of membrane processing;
Vergelijkbare producten zoals Applications of Membrane Technology for Food Processing Industries
Innovative and Emerging Technologies in the Bio-marine Food Sector
principles of application and the main technological developments achieved in recent years. It includes technological design, equipment and;
Vergelijkbare producten zoals Innovative and Emerging Technologies in the Bio-marine Food Sector
Microbiological Food Hygiene
Microbiological Food Hygiene is a book about our clean and healthy nutrition from the sources of raw food materials into our homes. It;
Vergelijkbare producten zoals Microbiological Food Hygiene
Engineering Principles of Unit Operations in Food Processing
Engineering Principles of Unit Operations in Food Processing, volume 1 in the Woodhead Publishing Series, In Unit Operations and Processing;
Vergelijkbare producten zoals Engineering Principles of Unit Operations in Food Processing
Food Analysis and Preservation
, microbiology, and more. The experimental investigations in this book focus on information regarding chemical and microbiological analysis as;
Vergelijkbare producten zoals Food Analysis and Preservation
Processing Foods
industrialists make use of new concepts, technologies and approaches that are at the heart of modern food research. It will be a useful tool in the;
Vergelijkbare producten zoals Processing Foods
Processing Foods
industrialists make use of new concepts, technologies and approaches that are at the heart of modern food research. It will be a useful tool in the;
Vergelijkbare producten zoals Processing Foods
Food Processing Technology
Food Processing Technology: Principles and Practice, Fourth Edition, has been updated and extended to include the many developments;
Vergelijkbare producten zoals Food Processing Technology
Food Analysis and Preservation
, microbiology, and more. The experimental investigations in this book focus on information regarding chemical and microbiological analysis as well;
Vergelijkbare producten zoals Food Analysis and Preservation
Sustainable Food Processing
processing. It will be of great interest to academic and industrial professionals. Opening chapters cover the concept and principles of sustainable;
Vergelijkbare producten zoals Sustainable Food Processing
Einde inhoud
Geen pagina's meer om te laden'